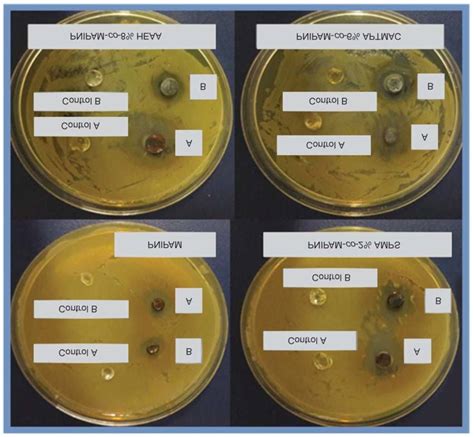

Pseudomonas Aeruginosa Culture Time Explained
Understanding Pseudomonas Aeruginosa Culture Time: A Deep Dive for Lab Pros
Hey lab wizards! Today, we’re diving deep into something super crucial for all you microbiologists out there: Pseudomonas aeruginosa culture time . Yeah, I know, it might sound a bit dry, but trust me, getting this right is absolutely essential for accurate diagnosis and effective treatment. If you’re working in a clinical lab, a research facility, or even a quality control setting, understanding the optimal incubation period for P. aeruginosa can make the difference between a quick, confident ID and a frustrating, time-consuming delay. So, grab your favorite lab coat, maybe a strong cup of coffee, and let’s get into the nitty-gritty of how long this notorious bacterium likes to hang out in the incubator before we can reliably spot it.
When we talk about Pseudomonas aeruginosa culture time , we’re essentially asking: “How long does it take for this bug to grow to a detectable level on our culture media?” This isn’t a one-size-fits-all answer, guys. Several factors come into play, and nailing them down is key. The type of specimen you’re dealing with is a huge one. Are you looking at a urine sample, a wound swab, sputum, or perhaps a sterile body fluid? Each of these has a different typical bacterial load and a different milieu that can either encourage or inhibit growth. For instance, urine samples might require a longer incubation if you’re suspecting a low-level UTI, whereas a high-volume sputum sample from a patient with cystic fibrosis might show growth much faster. The culture medium itself plays a massive role. Are you using a general-purpose agar like Blood Agar, or a selective and differential medium designed specifically for Gram-negative rods, like MacConkey Agar or Cetrimide Agar? Selective media are designed to suppress the growth of unwanted organisms, which can sometimes slow down the growth of your target P. aeruginosa a tad, but they are invaluable for isolating it from mixed cultures. Differential media, on the other hand, often rely on specific metabolic pathways of P. aeruginosa , like its ability to produce pigments or oxidase, which become evident over time. The inoculum size – how much bacteria you actually put on the plate – is another biggie. A heavy inoculation will obviously grow faster than a tiny, trace amount. And let’s not forget the incubation conditions : temperature, atmosphere (aerobic vs. anaerobic, though P. aeruginosa is primarily aerobic), and humidity all contribute to the growth rate. Generally, most clinical microbiology labs incubate plates at 35-37°C in an aerobic environment for 18 to 24 hours as a standard first read. However, for P. aeruginosa , especially in specimens where it’s expected in lower numbers or in the presence of competing flora, it’s often recommended to extend this incubation. We’re talking 48 hours , and sometimes even 72 hours , particularly for sterile sites or when a slow-growing organism is suspected. This extended incubation allows those sneaky, low-level infections to manifest, giving you a clearer picture and preventing those dreaded false negatives. So, while 24 hours is your standard checkpoint, keep those longer incubation periods in mind – they are your best friends for comprehensive Pseudomonas aeruginosa culture time analysis!
The Science Behind Pseudomonas Aeruginosa Growth Curves
Let’s geek out a bit more on the science behind Pseudomonas aeruginosa culture time . You see, bacteria don’t just magically appear on a plate; they go through predictable growth phases. Understanding these phases helps us pinpoint the optimal time for detection. When you first inoculate a culture medium, the bacteria are in the lag phase . They’re basically adjusting to their new environment, synthesizing enzymes, and preparing for rapid multiplication. This phase can vary depending on the initial physiological state of the bacteria and the richness of the medium. After the lag phase comes the logarithmic (log) or exponential phase . This is where the magic happens – bacteria are dividing rapidly, and their numbers are doubling at a constant rate. The generation time for P. aeruginosa under optimal conditions is typically around 20-30 minutes . This means that theoretically, one bacterium could become over a million in just about 10-12 hours! Pretty wild, right? However, this is happening in a complex clinical specimen or on an agar plate, not in a perfectly controlled flask. So, while the potential for rapid growth is there, the reality is often a bit slower. The visible colonies we see on an agar plate are the result of millions of bacteria multiplying from a single cell or a small cluster. For P. aeruginosa to form a visible colony, which is usually defined as around 50-100 cells , it needs enough time to complete several generations. This is why the standard 18-24 hour incubation is often sufficient for specimens with a high bacterial load. But what if your sample is borderline? Or what if the P. aeruginosa is stressed or competing with other microbes? This is where the stationary phase comes in. Eventually, the bacterial population runs out of nutrients, accumulates toxic waste products, or encounters other limiting factors, and the growth rate slows down and eventually stops. The bacteria are still viable, but they’re not actively multiplying anymore. Finally, there’s the death or decline phase , where the number of viable cells decreases. For diagnostic purposes, we want to catch the bacteria during their log phase when they are most metabolically active and abundant enough to be easily detected, but before the stationary phase complicates things too much. When we extend the Pseudomonas aeruginosa culture time to 48 or 72 hours , we are essentially giving those bacteria that might have had a longer lag phase, a smaller initial inoculum, or are growing in a less-than-ideal environment, more time to enter and reach a detectable density in their log phase. This extended period is particularly crucial for P. aeruginosa because it’s known for its adaptability and its ability to thrive in diverse environments, including those that are nutrient-poor or contain inhibitory substances. So, by patiently waiting a bit longer, we increase our chances of capturing this resilient pathogen, ensuring that our culture results are as sensitive and specific as possible. It’s all about respecting the bacterial growth curve, guys!
Factors Influencing Pseudomonas Aeruginosa Culture Time
Alright, let’s break down the key factors influencing Pseudomonas aeruginosa culture time . We touched on some of these earlier, but it’s worth elaborating because understanding these variables will help you troubleshoot and optimize your lab protocols. First up, we have the Specimen Type . As I mentioned, this is a game-changer. Think about it: a sputum sample from a cystic fibrosis patient is likely teeming with P. aeruginosa , whereas a routine urine sample might only have a few to identify a urinary tract infection. Sterile sites like blood or cerebrospinal fluid (CSF) require careful handling and potentially longer incubation because the bacterial load is expected to be very low, and any presence is significant. For wound infections, the sample matrix itself – pus, tissue, exudate – can affect bacterial viability and growth rate. Next, let’s talk about the Culture Medium . Not all plates are created equal! Selective media , like MacConkey Agar and Cetrimide Agar , are designed to inhibit Gram-positive bacteria and other contaminants, giving P. aeruginosa a better shot at growing. Cetrimide Agar, for instance, contains cetrimide, which inhibits the swarming motility characteristic of Proteus species and also inhibits Gram-positive bacteria, while enhancing the growth of Pseudomonas species. However, sometimes the very inhibitors in selective media can slightly slow down the growth of your target organism. Differential media often incorporate components that reveal P. aeruginosa ’s unique characteristics, such as pigment production (like pyocyanin, a bluish-green pigment) or oxidase activity. Pigment production often takes 24-48 hours to become clearly visible, further justifying extended Pseudomonas aeruginosa culture time . Using a combination of general and selective/differential media in parallel is often the best strategy. Then there’s the Inoculum Size . A large number of bacteria introduced to the plate will obviously grow faster than a small number. This is directly related to the specimen type and how it was collected and processed. A concentrated sample or a positive blood culture broth will yield faster results than a dilute swab. The Incubation Conditions are also paramount. Temperature is usually kept at 35-37°C , mimicking human body temperature, which is optimal for most clinically relevant bacteria. Atmosphere is typically aerobic for P. aeruginosa , as it’s an obligate aerobe (meaning it needs oxygen to grow). However, some protocols might involve specific atmospheric requirements, especially when used in conjunction with other tests. Humidity also plays a role; plates should be incubated in a humidified incubator to prevent them from drying out, which can inhibit bacterial growth. Finally, don’t overlook the Physiological State of the Bacteria . Bacteria that have been exposed to antibiotics, disinfectants, or harsh environmental conditions prior to collection might be stressed. Stressed bacteria may have a longer lag phase or grow more slowly, necessitating a longer incubation period. So, when you’re deciding on your incubation time, always consider the specimen source, the media used, and any known factors that might affect bacterial viability. It’s this holistic approach that ensures you’re giving P. aeruginosa the fair chance it needs to show itself on your plate!
Standard Incubation Periods and Extended Times
Let’s talk about the bread and butter – the standard incubation periods and when you might need to push it for extended times when culturing Pseudomonas aeruginosa . For most routine bacterial cultures in clinical microbiology, the standard first read is typically after 18-24 hours of incubation at 35-37°C aerobically. This timeframe is based on the growth characteristics of many common pathogens. For P. aeruginosa , this initial 24-hour period is often sufficient, especially if the specimen has a high bacterial load, like a positive blood culture or a heavily contaminated wound swab. You’ll likely see characteristic, often iridescent or greenish-tinged, colonies on appropriate media, possibly accompanied by the distinctive grape-like odor or pigment production. However, P. aeruginosa is notoriously adaptable and can sometimes be present in lower numbers, or it might be growing in a specimen with inhibitory substances or competing microflora. This is precisely why extending the Pseudomonas aeruginosa culture time is a critical practice. Many laboratories, including those following CLSI (Clinical and Laboratory Standards Institute) guidelines, recommend holding cultures for 48 hours for certain specimen types, and even up to 72 hours for others, particularly sterile sites or when slow-growing organisms are suspected. Why the extended time? Well, P. aeruginosa can exhibit slower growth rates under suboptimal conditions. For instance, in urine specimens where the bacterial count might be low, waiting an extra 24-48 hours can significantly increase the sensitivity of detection, potentially identifying infections that would be missed with a single 24-hour read. Similarly, in respiratory specimens like sputum or bronchial washings, especially from immunocompromised patients or those with chronic lung conditions like cystic fibrosis where P. aeruginosa is a common colonizer and pathogen, extended incubation allows for the detection of lower-level or intermittent shedding. For blood cultures, although automated systems provide continuous monitoring, sub-culturing to agar plates might still benefit from longer incubation if initial growth is equivocal or delayed. The 48-hour incubation is a common second read point for many labs. It allows for the development of subtle characteristics like faint pigment production or slower colony expansion. If you’re using differential media, waiting until the 48-hour mark might be necessary to observe definitive biochemical reactions or pigment patterns that confirm the Pseudomonas identification. In some specific scenarios, such as investigating environmental samples for contamination or when dealing with particularly fastidious or slow-growing strains, incubation can be extended even further, potentially to 5-7 days . However, for standard clinical diagnostics, 48 hours is the most common and practical extension. It strikes a balance between ensuring adequate sensitivity and maintaining laboratory workflow efficiency. So, remember: 18-24 hours is your first check, but don’t hesitate to extend to 48 hours – and sometimes even 72 hours – to catch those elusive P. aeruginosa cases and ensure comprehensive patient care. It’s all about giving the bug enough time to reveal itself!
Recognizing Pseudomonas Aeruginosa Colonies: Beyond Simple Time
So, you’ve given your cultures the appropriate Pseudomonas aeruginosa culture time , and now it’s time to look at those plates. But how do you confidently identify P. aeruginosa colonies? It’s not just about waiting the right amount of time; it’s about knowing what to look for! While P. aeruginosa is relatively easy to identify on standard media compared to some other bacteria, recognizing its characteristic features is key to accurate interpretation. First off, let’s talk colony morphology . On non-selective media like Blood Agar , P. aeruginosa typically produces medium-sized (2-3 mm), round, smooth colonies with a flat to slightly raised appearance. A very important characteristic is motility , which can manifest as swarming on some media, although this is less common and often suppressed on selective agars. A more consistently observed feature is the production of pigments . P. aeruginosa is famous for its ability to produce a variety of water-soluble pigments. The most distinctive is pyocyanin , a bluish-green pigment that is often visible on the surface of the colony and can diffuse into the agar. This pigment is often associated with a characteristic sweet, fruity, grape-like odor , which is a strong clue, especially when you’re working with multiple cultures. Other pigments include pyoverdine (a greenish-yellow fluorescing pigment) and sometimes pyorubin (a reddish-brown pigment) or melanin (a black pigment), though pyocyanin and pyoverdine are the most commonly encountered in routine diagnostics. These pigments usually become more pronounced after 24-48 hours of incubation, reinforcing the need for that extended Pseudomonas aeruginosa culture time . On MacConkey Agar , which is selective for Gram-negative bacteria and differentiates based on lactose fermentation, P. aeruginosa are non-lactose fermenters (NLFs) . This means their colonies will appear pale or colorless , contrasting with the pink or red colonies of lactose-fermenting bacteria like E. coli . This differential characteristic is a major diagnostic aid. On Cetrimide Agar , specifically designed to select for Pseudomonas species, P. aeruginosa colonies often appear greenish due to pigment production. Beyond visual cues, further biochemical tests are usually performed for definitive identification. The oxidase test is a crucial early step; P. aeruginosa is typically oxidase-positive , meaning it rapidly oxidizes a reagent (like tetramethyl-p-phenylenediamine) producing a purple color. This test can often be performed directly from the colony on the agar plate. Other biochemical tests, such as citrate utilization, motility, and API strips (automated identification systems), are then used to confirm the species. So, while time is a critical factor in Pseudomonas aeruginosa culture time , don’t underestimate the importance of carefully observing colony morphology, noting any characteristic odors, and looking for pigment production. Combining these visual clues with rapid biochemical tests will give you the confidence to identify P. aeruginosa accurately and efficiently, ensuring timely and appropriate patient management. It’s a combination of patience and sharp observation, guys!
Troubleshooting Delayed or Negative Cultures
What happens when your Pseudomonas aeruginosa culture time yields disappointing results – a delayed growth or even a negative plate when you strongly suspect infection? Don’t panic! There are several common culprits and troubleshooting steps you can take. One of the most frequent issues is inadequate specimen collection or transport . If the swab dried out, if the transport medium was incorrect, or if the specimen sat at room temperature for too long, the bacteria might have died or become stressed, leading to delayed or absent growth. Ensure you’re using the correct collection devices and that specimens are transported to the lab promptly under appropriate conditions (e.g., refrigerated for some samples, but not all!). Another major factor is the presence of antibiotics . If the patient has been on antibiotics, even prior to sample collection, these drugs can significantly inhibit or kill P. aeruginosa . This is particularly relevant in clinical settings where empirical antibiotic therapy is common. In such cases, you might need to extend incubation times significantly, potentially up to 72 hours or more , or use specialized media designed to overcome antibiotic inhibition. Sometimes, the culture medium itself might be the issue . Expired media, improper storage, or using a medium that isn’t optimal for P. aeruginosa can lead to poor growth. Always check expiry dates and ensure you’re using media that is appropriate for the specimen type and suspected pathogens. Selective media, while helpful, can sometimes be too inhibitory if not formulated correctly or if the organism is slightly inhibited by the selective agents. Low bacterial inoculum is another common reason for delayed or missed detection. If the infection is early stage, or if the sample was taken from a site with very low bacterial concentration, you might simply not have enough bacteria to form visible colonies within the standard timeframe. This is where extending the incubation period becomes absolutely vital. Re-incubating plates for an additional 24-48 hours can often reveal growth that was initially missed. Improper incubation conditions can also be a problem. Ensure your incubator is calibrated correctly for temperature and that there’s adequate humidity. P. aeruginosa requires aerobic conditions, so ensure your incubator isn’t accidentally creating an anaerobic environment. Sometimes, over-incubation can lead to colony lysis or overgrowth by other bacteria, making identification difficult. This is why adhering to recommended incubation times, including those extended periods, is important. If you suspect a specific type of P. aeruginosa that is known to be slow-growing or fastidious, you might need to consult specialized protocols or reference materials. Finally, don’t rule out technical error during plating or reading. Ensure proper aseptic technique is used, and that plates are read by experienced personnel. If you consistently get negative results when clinical suspicion is high, it might be worth reviewing your entire workflow, from collection to reporting. So, if your P. aeruginosa cultures are looking a bit sad, systematically go through these potential issues. Extending incubation is often your first and best bet, but a thorough review of your process can save you a lot of headaches and ensure you’re not missing this important pathogen!
Conclusion: The Art and Science of Waiting for Pseudomonas
So there you have it, guys! We’ve journeyed through the nuances of Pseudomonas aeruginosa culture time , exploring everything from the basic growth phases to the intricate factors that influence how long this resilient bacterium needs to make itself known on our agar plates. It’s clear that while 18-24 hours is a standard starting point, it’s often just the beginning of the story for P. aeruginosa . The ability to adapt and thrive in diverse environments means that sometimes, you just need to be patient . Extending the Pseudomonas aeruginosa culture time to 48 hours , and in some cases even 72 hours , is not just a recommendation; it’s a crucial step in ensuring diagnostic accuracy and improving patient outcomes. By understanding the science behind bacterial growth curves, recognizing the characteristic colonial morphology and pigmentation, and troubleshooting potential issues like antibiotic interference or low inoculum, we can become more adept at detecting this significant pathogen. Remember, in the world of microbiology, time is not just a measurement; it’s a critical variable. Giving P. aeruginosa the appropriate incubation period is an art that combines scientific knowledge with practical experience. So, the next time you’re staring at a culture plate, remember the little bugger might just need a little more time to show its true colors – literally! Keep up the great work in the lab, and happy culturing!